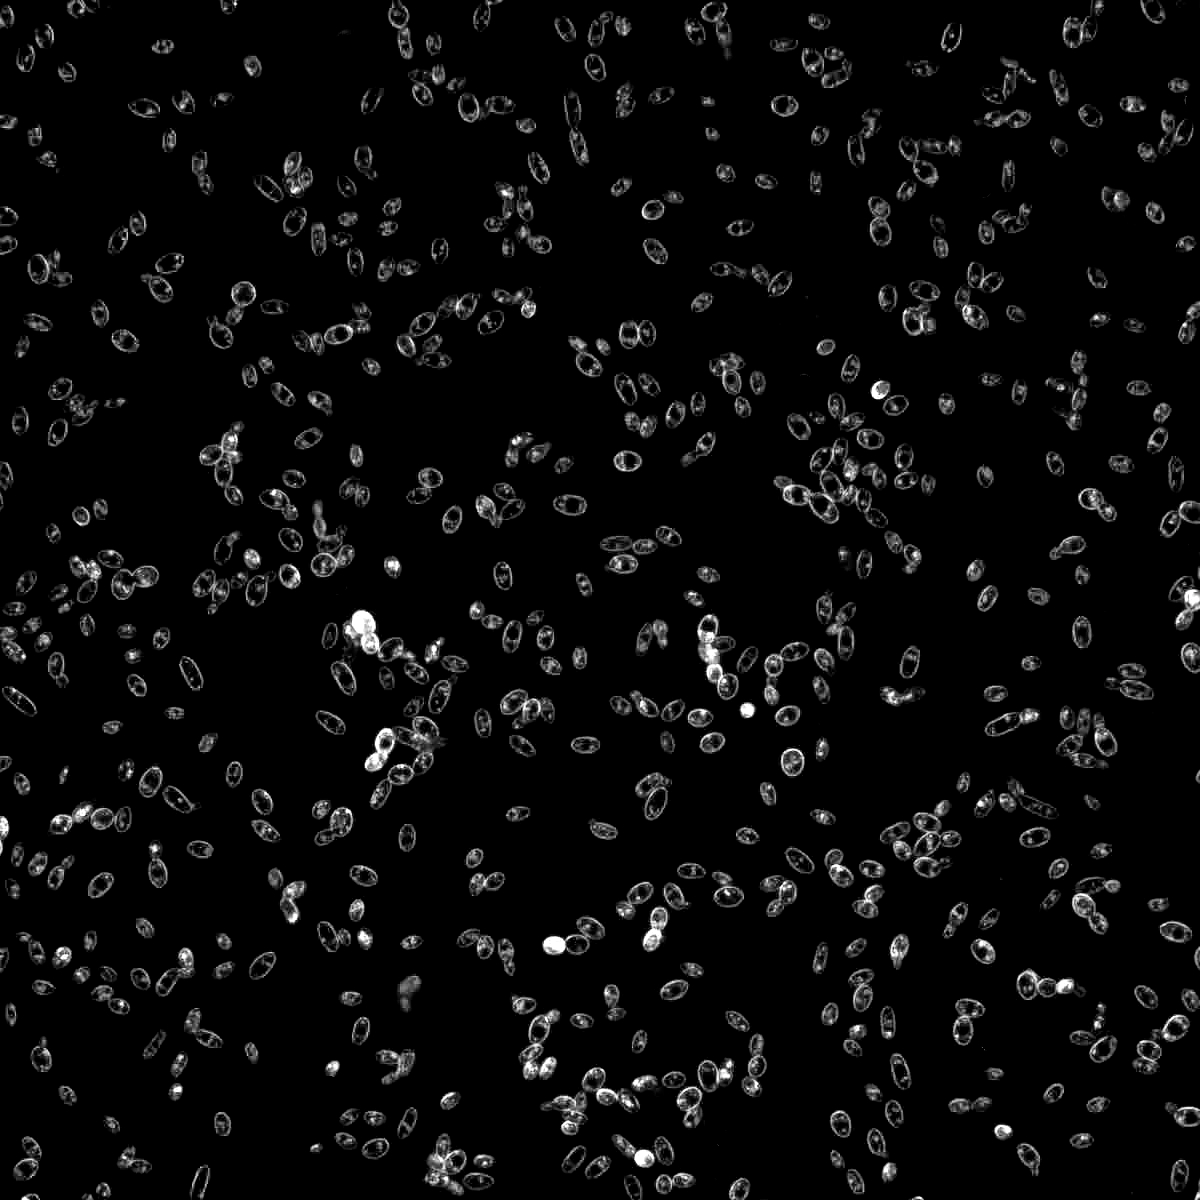
1214

Strain: 1214
Belgian Abbey Style Ale
Species: Saccharomyces cerevisiae
Profile: A widely used and alcohol tolerant Abbey style yeast that is suitable for a variety of Belgian style ales. This strain produces a nice ester profile as well as slightly spicy alcohol notes. It can be slow to start; however, it attenuates well.
Used in:
-
Flocculation
Low Medium -
Apparent Attenuation
74 - 78% -
Apparent ABV Tolerance
12% -
Temperature Range
68-78°F (20-26°C) -
Phenolic Off Flavor
Positive